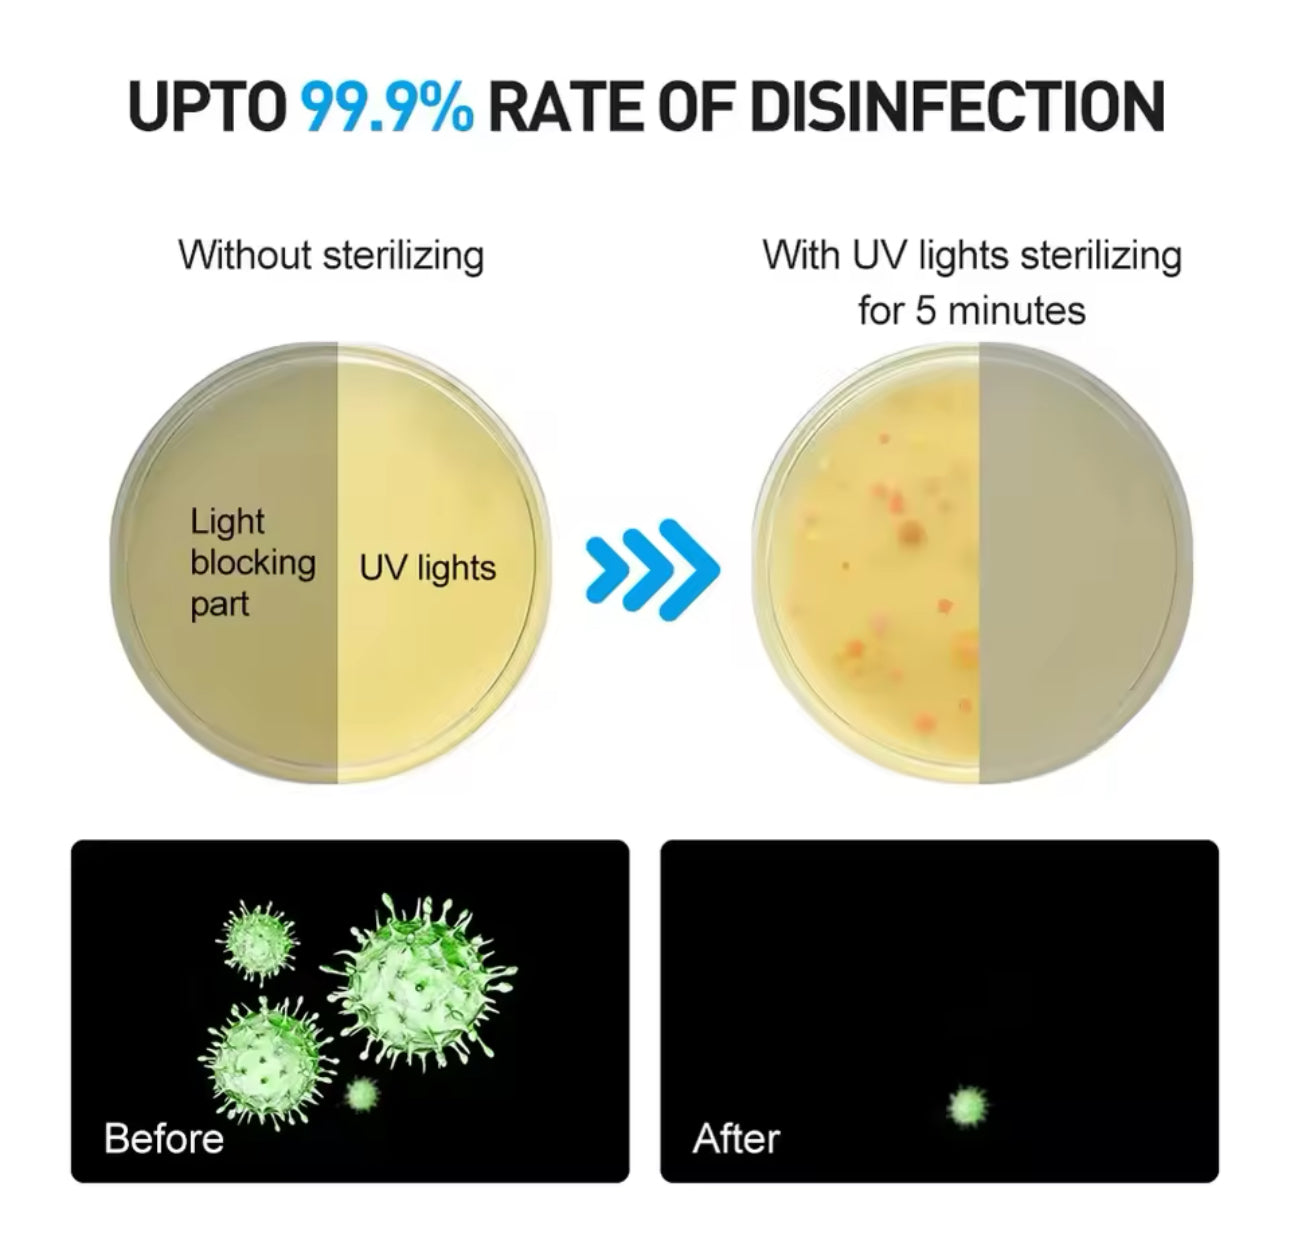
Esterilizador de pinzas Luz UV

Esterilizador de pinzas Luz UV
Esterilizador de pinzas Luz UV
Precio habitual
$ 155.00 MXN
Precio habitual
$ 299.00 MXN
Precio de oferta
$ 155.00 MXN
Precio unitario
/
por
No se pudo cargar la disponibilidad de retiro
Envío Gratis
Envío Gratis
El envió es totalmente gratis
El tiempo de procesamiento es de 2 a 3 días hábiles
Tiempo de envió Tarda de 5 a 8 días hábiles
Envios Nacionales
Envios Nacionales
Todos los Envíos Nacionales tardan de 1 a max 2 días en ser procesados tiempo de entrega de 2 a 3 días hábiles con costo adicional
Garantía de Reembolso 5 dias
Garantía de Reembolso 5 dias
Todo pedido Dañado o Defectuoso o en Mal estado sera reembolsado tu dinero de inmediato plazo de devolución es de 5 días
- El tiempo de desinfección es de aproximadamente 3 minutos.
- con lámpara ultravioleta grande de dos lados 360°C esterilización
- con función de aroma, perfumes variados opcionales
- Con gran capacidad, adecuado para la mayoría de teléfonos móviles de
6 pulgadas, pinzas, brochas de maquillaje, espejos, limas de uñas, herramientas exfoliantes, máscaras, juguetes, ropa interior y joyería.
5 dimensión inteligente y baja tensión de 5V, pestable y seguro.